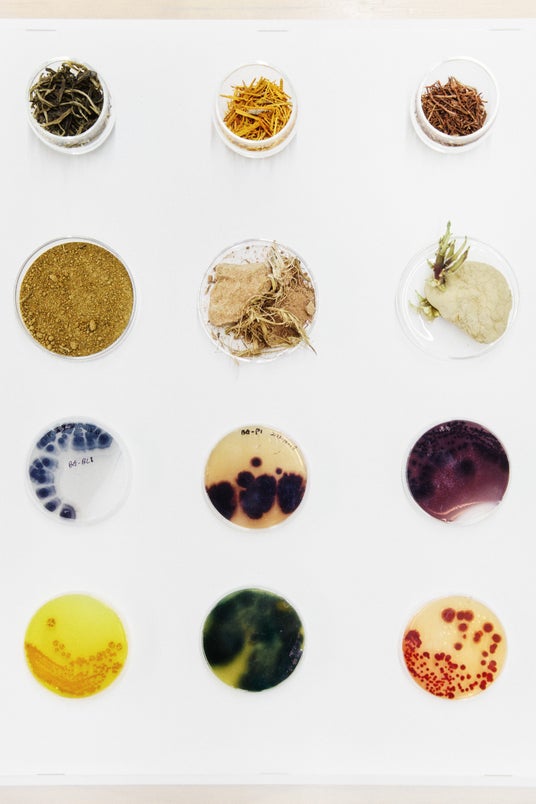

株式会社NONE
「DORAVIIE(ドラヴィ)」24SSのコレクションは自然の湖、砂丘、光と影などにインスピレーションを受け、もちろん素材も自然環境に由来する。8月9日(金)13:00よりイベント開始。

DORAVIIE CITY FREE SOUL COLLECTION
DORAVIIE CITY FREE SOUL COLLECTION
(N)ONE ATELIER(エヌワンアトリエ)が国内正規販売代理店を務めるSDGsブランドDORAVIIE(ドラヴィ)が東京で期間限定POP UPを開催。
ブランドコンセプト
地球を守るためのブランドとして設立された「DORAVIIE」は、自然と調和したファッションを提案する天然染色SGDsブランドです。DORAVIIE創設は、環境への負荷を最小限に抑えながら、美しい色彩と高品質な素材を融合させることを目指しています。天然染色技術を現代に復活させ、自然の色彩が持つ力を最大限に引き出すことに専念しています。
DORAVIIEは、化学染料を一切使用せず、植物、果物、花、そして鉱物から得られる天然の色素のみを使用しています。これにより環境に優しいだけでなく、肌にも優しい製品を提供しています。自然の美しさと調和しながら、ファッションに新たな価値を見出すことが私たちの使命です。
自然を尊重したライフスタイルの世界に足を踏み入れ、毎日を快適に楽しんでいただきたいです。私たちは、自然が人に自信と自己表現を引き出す力を持っていると信じています。
DORAVIIE CITY FREE SOUL コレクション紹介
インスピレーション:
花、湖、砂丘、光と影、あらゆる自然の要素からインスピレーションを得て、天然のプリントや染色素材を組み合わせ、自然から生まれ、自然に還り、自然を身にまとい、感じることを出発点としています。自然をライフスタイルに溶け込ませ、消費者がゆっくりとした時間の経過の中で製品の美しさを感じるようにしています。
テクニック:
繊細かつ大胆な16本編みが身体にフィットすると同時に、清涼感を控え目に表現します。
さまざまな体型に対応する幅広のカーブエッジを使用し、常にどこかエレガントな印象を演出するアイテムが多く、それぞれの重ね着も可能です。
毛玉になりにくく、抗菌性に優れ、長持ちするカラーを使用しているので様々なウール・ベーシック素材と組み合わせることで、保温性や通気性を実現すると共にスタイリングも自由自在にしています。

Plant dye Eco-cotton Tank Top
Plant dye Eco-cotton Tank Top
Plant Dye Ultrafine Wool Top
材料:
カシミヤ、ウール、コットンなどの天然素材をメインに、伸縮性のある繊維を混紡し、アウトドア感覚の都会的なウェアを生み出しています。日常着にも適していながら、いつでもアウトドアアクティビティにも使用できます。誰にとっても現代の衣服から感じられる美しさを損なうことなく、満足のいく快適さを感じられる素材が選ばれています。都市とアウトドアのテーマの間で対応する最良のバランスを実現します。

Plant Dye Knitted Polo shirt
Plant Dye Airchill Shirt
Plant Dye Airchill Shirt
色彩:
すべての製品はバイオプリンティングから派生しています。製品範囲には、古典的な絞り染め、ドロップダイ、スクリーンプリントが含まれます。色素源としては、イサティス根の廃棄葉、栗の殻、ザクロの皮、茜、ヘマトキシリンなどが挙げられます。

サステナビリティへの取り組み
DORAVIIEは、自然で持続可能なライフスタイルと都市の中での快適さを常に感じられるような使い方と着こなしを望んでいます。また、例えば自転車に乗ったり、ハイキングしたり、ダンスしたりする必要があるときは、いつでも服装に縛られることなく自由に好きなアクティビティをすることができます。私たちが追い求めるのは、プロのアウトドアブランドではなく、都会の生活の中でいつでも自然を体感しながら、リラックスした気持ちでいつでも気軽にライトなアウトドアスポーツができることです。
【詳細】
DORAVIIEの日本市場への進出を記念して、スペシャルなプロモーションを実施いたします。詳細は、公式ウェブサイトやSNSアカウントで随時発表いたします。
・BRAND:DORAVIIE(ドラヴィ)
・SNS:https://www.instagram.com/doraviie_official/
・POPUP開催期間:2024年8月9日(金)~15日(月)
9日 13:00~19:30(19時最終入場)
10~11日 12:00~19:30(19時最終入場)
12~15日 12:00~19:30
・POPUP開催場所:東京都渋谷区神宮前3丁目15-8











